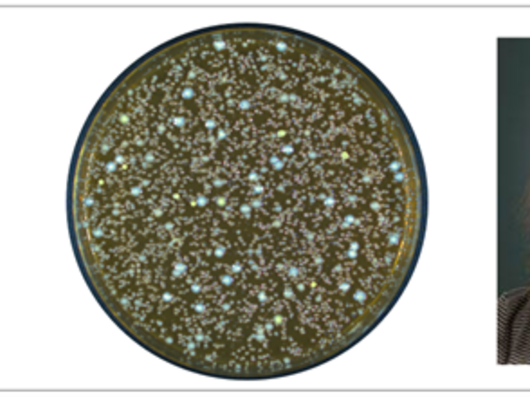
Collage mit den Portraitfotos eines Mannes und einer Frau, in der Mitte befindet sich ein Kreis mit bunt gefärbten Punkten. Es handelt sich vermutlich um die Aufnahme unter einem Mikroskop.

Sehr geehrte Besucherin, sehr geehrter Besucher,
das Institut für Medizinische Mikrobiologie an der Uniklinik RWTH Aachen wird seit September 2014 von mir geleitet und ist aktiv in der Ausbildung von Medizinern und Naturwissenschaftlern sowie der Erforschung des Darmmikrobioms sowie der Epidemiologie, Pathogenese und Immunabwehr von Infektionserkrankungen. Schwerpunkte sind epidemiologische Arbeiten zu Streptokokken-Infektionen durch das Nationale Referenzzentrum für Streptokokken, neue Formen der antibakteriellen Therapie (antimikrobielle Peptide, Phagen), Studien zur mikrobiellen Pathogenese und mukosalen antimikrobiellen Wirtsabwehr vor allem gegenüber enteropathogenen Viren, Parasiten und Bakterien sowie die funktionelle Charakterisierung kommensaler Bakterien und Fragen zur Bedeutung des intestinalen Mikrobioms. Auf den folgenden Seiten können Sie sich einen Überblick über unsere Aufgaben und wissenschaftlichen Schwerpunkte verschaffen.
Ihr
Univ.-Prof. Dr. med. Mathias Hornef (Direktor)
Institutsdirektor
Univ.-Prof. Dr. med. Mathias Hornef
Tel.: 0241 80-89510
mhornefukaachende
Sie treten durch den Haupteingang ein und gehen geradeaus bis zum Aufzug D4 (am hinteren Ende des Gebäudes). Mit dem Aufzug D4 fahren Sie in die 5. Etage, Eingang Medizinische Mikrobiologie. (Einen Wegeleitplan finden Sie hier.)
Foto Prof. Hornef: © Peter Winandy, im Auftrag der RWTH für die RWTH Homepage
Aktuelles aus dem Institut für Medizinische Mikrobiologie
News

Neue DFG-Förderung – Untersuchung der Motilität von V. cholerae im Schleim
AG Grognot erhielt einen neuen Zuschuss von der DFG, um zu erforschen, wie das bakterielle Pathogen Vibrio cholerae in Schleim und schleimähnlichen Umgebungen schwimmt. Das Projekt umfasst 3D-Tracking…

Mathias Hornef spricht auf der LAMIG Konferenz in Bogota, Kolumbien
Die Latin American Mucosal Immunology Group (LAMIG) Konferenz fand vom 13. bis 15. November 2025 in Bogota, Kolumbien statt und versammelte Wissenschaftler und Wissenschaftlerinnen aus Mittel- und…

Aachener Wissenschaftler unter den weltweit am häufigsten zitierten Forschenden
Dr. rer. nat. Thomas Clavel, Leiter der Research Group Functional Microbiome im Institut für Medizinische Mikrobiologie, und Univ.-Prof. Dr. rer. nat. Ralf Weiskirchen, Direktor des Institut für…

Nour Diab verteidigt erfolgreiche ihre Doktorarbeit
Am Dienstag, den 18. September, verteidigte Nour Diab aus dem Hornef-Labor erfolgreich ihre Doktorarbeit mit dem Titel „The Immunomodulatory role of Salmonella SopB delays early neonatal mucosal…

Paper of the month: Preisträger Matthias Schmitz
Genaue Proteinvorhersagen sind entscheidend für das Verständnis der Funktionen des Mikrobioms und die Erforschung von Mikroben-Wirt-Interaktionen. Matthias Schmitz, Thomas Hitch und ihr Team haben…

EMIG 2025: Das 13. Treffen der European Mucosal Immunology Group in Aachen
Vom 21. bis 23. Juli 2025 waren mehr als 150 Wissenschaftlerinnen und Wissenschaftler aus aller Welt zu Gast in Aachen. Die Tagung EMIG 2025 (EMIG2025) fand im CT² - Center for Teaching und Training…
Vom ERS Seed Fund der RWTH Aachen geförderte Forschung der AG Joel Selkrig erforscht Mikroben und Schmerzwahrnehmung
Joel Selkrig (Institut für Medizinische Mikrobiologie, Medizinische Fakultät) und Gaia Tavosanis (Lehrstuhl für Entwicklungsbiologie, Biologische Fakultät) haben einen ERS Seed Fund der RWTH Aachen…

Erfolg für die Mikrobiomforschung: Drittmittel für Prof. Clavel und Prof. Selkrig im SPP 2474 eingeworben
Sehr gute Neuigkeiten! Prof. Tom Clavel und Prof. Joel Selkrig haben erfolgreich Forschungsdrittmittel im Rahmen des SPP 2474 Priority Program „Illuminating Gene Functions in the Human Gut Microbiome“…

Pint of Science in Aachen
Wir hatten eine großartige Zeit beim Pint of Science in Aachen - gutes Bier und noch bessere Gesellschaft! Joel Selkrig eröffnete am 19.Mai 2025 die Veranstaltung mit einem Vortrag über unseren Körper…

Univ.-Prof. Dr. Thomas Clavel, Professor am Institut für Medizinische Mikrobiologie veröffentlicht Fachartikel in der renommierten Fachzeitschrift Nature Biotechnology
Univ.-Prof. Dr. Thomas Clavel, Professor am Institut für Medizinische Mikrobiologie an der Uniklinik RWTH Aachen, konnte in Zusammenarbeit mit Kolleginnen und Kollegen den Fachartikel „Enabling…

Publikation von Stefan Schlößer und Anna-Lena Ullrich in PNAS
Die langjährige Forschungsarbeit von Stefan Schlößer, die anschließend von Anna-Lena Ullrich weitergeführt wurde, wurde in The Proceedings of the National Academy of Sciences (kurz: PNAS) zur…

Scientific Symposium: Prof. Thomas Clavel als Speaker zu Gast in der Goethe Universität Frankfurt
Die Goethe-Universität Frankfurt lädt mit freundlicher Unterstützung der Friedrich-Merz-Stiftungsgastprofessur zum „Symposium Dietary and therapeutic microbiomemodulation: State of The Art and…

Veranstaltungen
Aktuell keine Veranstaltungen